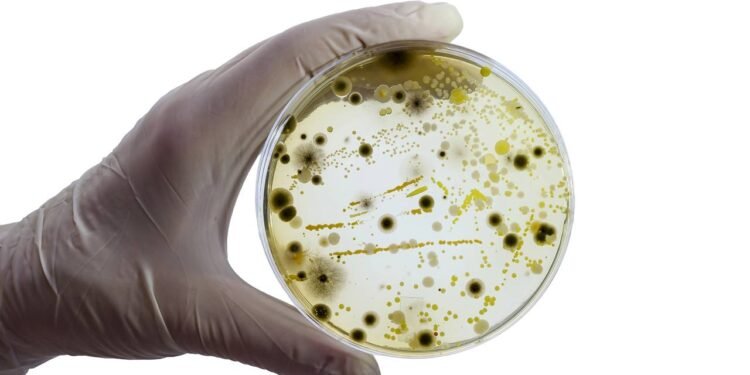
A regra dos 5 segundos é real? O que a ciência diz sobre a comida que cai no chão

A regra dos 5 segundos é conhecida popularmente como a ideia de que um alimento que cai no chão pode ser consumido com segurança se for recolhido rapidamente. Essa noção circula há décadas em conversas informais, mas também despertou interesse científico. Pesquisadores de microbiologia e segurança dos alimentos passaram a investigar se o tempo de contato com o piso realmente define a quantidade de bactérias que passa para a comida. Portanto, a discussão deixou de ser apenas um “ditado popular” e passou a envolver dados, experimentos e análises quantitativas sobre risco de contaminação.
Na prática, o que as pesquisas vêm mostrando é que a contaminação de um alimento que toca o chão depende de vários fatores combinados. Tipo de comida, umidade, textura da superfície, quantidade de microrganismos presentes e tempo de contato influenciam o processo. Então, o relógio conta, mas não é o único elemento relevante, e em algumas condições a transferência bacteriana ocorre de forma quase imediata. Em suma, a realidade é mais complexa do que a simples contagem de segundos sugerida pela regra dos 5 segundos.
A regra dos 5 segundos é real?
Estudos de laboratório realizados nos últimos anos indicam que a chamada regra dos 5 segundos não se sustenta como garantia de segurança. Em ambientes controlados, testes demonstraram que bactérias conseguem migrar da superfície contaminada para o alimento nos primeiros instantes de contato, muitas vezes em frações de segundo. Em alguns experimentos, alimentos ficaram contaminados mesmo quando foram retirados do chão em menos de 1 segundo. Portanto, não existe um “tempo mágico” que impeça a contaminação.
Isso não significa que o tempo seja irrelevante. Em vários trabalhos, observou-se que períodos mais longos, como 30 segundos ou 1 minuto, tendem a aumentar a carga de microrganismos transferidos. Entretanto, a principal mensagem dos pesquisadores é que o simples fato de tocar uma superfície suja já representa risco potencial, independentemente de o alimento ficar ali por 2, 5 ou 10 segundos. Em suma, a regra funciona mais como um mito cultural do que como uma diretriz de segurança alimentar.
Além disso, especialistas em saúde pública destacam que certos grupos correm mais risco quando ingerem alimentos possivelmente contaminados, como crianças pequenas, idosos, gestantes e pessoas imunossuprimidas. Então, o que para um adulto saudável pode resultar “apenas” em um desconforto leve, para esses grupos vulneráveis pode trazer complicações mais sérias, como infecções gastrointestinais intensas.
O que a ciência diz sobre a transferência de bactérias em alimentos úmidos e secos?
A palavra-chave para entender o comportamento das bactérias é umidade. Alimentos úmidos, como fatias de melancia, morangos cortados, pedaços de carne ou pão com recheio pastoso, facilitam a adesão e o movimento dos microrganismos. Em estudos microbiológicos, esse tipo de alimento costuma apresentar taxas de transferência muito mais altas do que itens secos, como biscoitos simples, torradas ou balas duras. Portanto, a água presente na comida funciona, em muitos casos, como um “meio de transporte” para os microrganismos.
Quando uma comida com água em sua composição cai sobre uma superfície contaminada, forma-se um ambiente favorável para que as bactérias “deslizem” e se fixem. Já produtos com baixa atividade de água tendem a absorver menos microrganismos nesse primeiro contato, embora a contaminação ainda ocorra. Em testes comparativos, pesquisadores observaram que:
- Alimentos úmidos apresentam alta transferência bacteriana quase imediata.
- Alimentos secos costumam receber menor carga no mesmo intervalo de tempo.
- Mesmo alimentos secos podem atingir níveis preocupantes se permanecerem por mais tempo em superfícies muito sujas.
Em muitos experimentos, a diferença entre úmidos e secos foi mais significativa do que a variação entre 5 e 10 segundos de contato. Isso ajuda a explicar por que a regra dos 5 segundos simplifica demais um fenômeno que envolve várias variáveis físicas e biológicas. Então, ao avaliar se vale a pena comer algo que caiu, considerar se o alimento é seco ou úmido torna-se crucial.
Além do risco imediato, alimentos úmidos que sofrem contaminação podem favorecer, ao longo do tempo, a multiplicação de certas bactérias quando permanecem em temperatura ambiente. Portanto, se um alimento úmido cai no chão e a pessoa decide guardá-lo “para comer depois”, o risco de crescimento microbiano aumenta ainda mais, sobretudo em climas quentes e úmidos.
Como a superfície do chão interfere na regra dos 5 segundos?
Outro ponto central para a segurança dos alimentos que caem no chão é o tipo de superfície. Pesquisas em microbiologia ambiental analisaram materiais como azulejo, aço inoxidável, madeira e carpete. Cada um deles apresenta rugosidade, porosidade e capacidade de reter sujeira diferentes, o que modifica a taxa de transferência bacteriana. Portanto, não basta olhar apenas para o “tempo” ou para o alimento: o chão também pesa bastante na equação.
De forma geral, superfícies lisas, como azulejo e aço inox, tendem a permitir uma transferência mais eficiente, porque as bactérias ficam mais expostas e disponíveis na camada superficial. Pisos porosos ou com fibras, como madeira não selada e carpete, podem reter microrganismos em camadas mais profundas, o que às vezes reduz a quantidade que chega imediatamente ao alimento, mas aumenta a dificuldade de higienização completa.
- Azulejo e aço inox: costumam apresentar alta transferência logo nos primeiros segundos.
- Madeira: comporta-se de forma variável, dependendo do tipo de tratamento e acabamento.
- Carpete: pode prender parte das bactérias, mas também acumula sujeira e resíduos orgânicos ao longo do tempo.
Vale destacar que, nos experimentos, as superfícies são geralmente inoculadas com bactérias específicas em quantidades controladas. No dia a dia, a carga microbiana de um piso doméstico ou de um ambiente público depende de limpeza, circulação de pessoas, presença de animais e outros fatores de higiene. Em suma, o chão da cozinha de uma casa bem cuidada não oferece o mesmo risco que o piso de um banheiro público, por exemplo.
Então, se a pessoa derruba um alimento em uma área de grande circulação, como shoppings, escolas, restaurantes movimentados ou estações de transporte, o nível de incerteza e de contaminação potencial cresce bastante. Portanto, a recomendação prática dos especialistas tende a ser mais rígida nesses ambientes: evitar consumo de alimentos que tocaram o piso, mesmo que por um tempo muito curto.
Existe uma “velocidade exata” para a contaminação dos alimentos?
Os estudos microbiológicos que medem a velocidade de transferência não apontam um único valor universal. Em vez disso, descrevem faixas de tempo e proporções de bactérias que passam para a comida em diferentes cenários. Em muitos casos, uma parcela significativa da contaminação ocorre nos primeiros segundos, com aumento gradual à medida que o alimento permanece em contato com a superfície. Em suma, a transferência bacteriana não segue um cronômetro simples, mas um conjunto de interações entre microrganismo, alimento e ambiente.
Alguns experimentos mostraram que a maior parte da transferência pode acontecer nos primeiros 5 a 30 segundos, especialmente em alimentos úmidos sobre pisos lisos. Em outros, o crescimento foi mais progressivo, indicando que tanto o tipo de microrganismo quanto a condição ambiental interferem nesse ritmo. Assim, a ideia de uma “barreira de segurança” baseada apenas em segundos não encontra respaldo sólido na literatura científica.
- O contato inicial já é suficiente para iniciar a contaminação.
- O tempo adicional tende a aumentar a carga bacteriana, mas em graus variados.
- A combinação de umidade, superfície e limpeza do ambiente pesa tanto quanto o relógio.
Portanto, em vez de contar segundos, faz mais sentido avaliar o contexto: onde o alimento caiu, em que tipo de piso, qual é o estado de limpeza aparente, que tipo de comida é e quem vai consumi-la. Então, a decisão deixa de ser um reflexo automático baseado em uma regra popular e passa a se apoiar em critérios de risco um pouco mais racionais.
O que esses estudos indicam sobre hábitos no dia a dia?
A regra dos 5 segundos, apesar de popular, não é reconhecida como critério confiável de segurança alimentar. Pesquisas reforçam que o simples ato de cair no chão pode ser suficiente para que um alimento entre em contato com bactérias potencialmente patogênicas. Cada ambiente apresenta um nível de risco diferente, e não há como medir isso a olho nu. Em suma, o que parece limpo nem sempre está livre de microrganismos.
Por esse motivo, especialistas em segurança dos alimentos costumam enfatizar a importância de práticas de higiene, como manter superfícies limpas, evitar o consumo de alimentos que caíram em locais desconhecidos ou de grande circulação e dar atenção especial aos alimentos úmidos e prontos para consumo. Assim, a compreensão científica da transferência bacteriana ajuda a ajustar expectativas sobre a regra dos 5 segundos, que permanece como expressão popular, mas sem respaldo como garantia de proteção.
Então, na rotina doméstica, algumas orientações práticas podem reduzir riscos: limpar pisos e bancadas com regularidade, evitar que animais circulem em áreas de preparo de alimentos, armazenar comidas prontas em recipientes fechados e descartar alimentos que caíram em superfícies suspeitas. Portanto, a prevenção, aliada à informação, torna-se o melhor caminho para lidar com o tema sem alarmismo, mas também sem falsa sensação de segurança.
FAQ – Perguntas adicionais sobre a regra dos 5 segundos
1. Lavar o alimento que caiu no chão resolve o problema?
Em suma, lavar pode reduzir parte da sujeira visível, mas não garante remoção completa de bactérias aderidas, principalmente em alimentos porosos ou com fissuras, como pão ou frutas com casca fina. Em muitos casos, a água da torneira não elimina microrganismos patogênicos de forma confiável.
2. A regra dos 5 segundos vale mais para alimentos industrializados embalados?
Se o alimento ainda está com a embalagem íntegra e esta cai no chão, o risco de contaminação interna é bem menor. Entretanto, é recomendável higienizar a embalagem antes de abrir, principalmente se ela tocou superfícies muito sujas ou de uso público.
3. Cozinhar depois de cair no chão torna o alimento seguro?
O calor adequado reduz significativamente muitas bactérias, mas não remove toxinas já produzidas por alguns microrganismos. Portanto, mesmo que o cozimento ajude, não existe garantia absoluta de segurança se o alimento entrou em contato com uma superfície altamente contaminada.
4. Crianças podem adoecer mais facilmente ao comer algo que caiu?
Sim. O sistema imunológico infantil ainda está em desenvolvimento, então crianças tendem a ser mais vulneráveis a infecções alimentares. Então, para esse grupo, a recomendação é ainda mais rígida: evitar consumo de alimentos que tocaram o chão.
5. Existe alguma situação em que o risco de comer algo que caiu seja menor?
O risco tende a ser menor quando o alimento é seco, cai em superfície visivelmente limpa, em ambiente doméstico bem higienizado, e a pessoa que irá consumir é saudável. Entretanto, mesmo nessas condições, o risco não zera; ele apenas diminui em comparação com outros cenários.